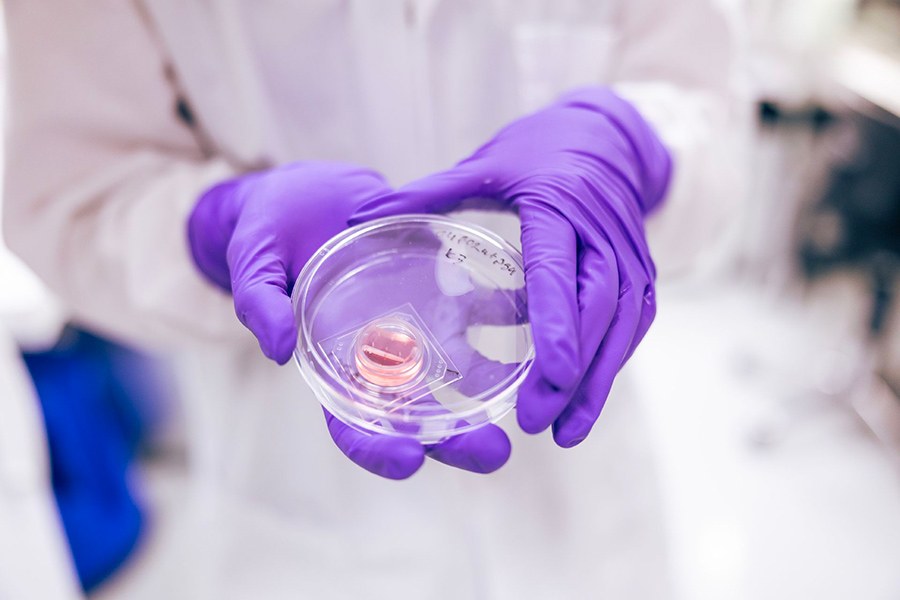
malli e

A body-on-a-chip is essentially a tiny lab that simulates the functions of human tissue using cells as basic components. Multi-tissue models can be linked together, creating multi‑tissue systems where different chambers represent the different organs. These models allow researchers to observe how organs interact, uncover disease mechanisms and evaluate drug efficacy.
Even though “modelling disease mechanisms” may sound abstract, the goals are very concrete: better diagnostics and treatments with less reliance on animal testing.
Animal experiments produce useful data but also come with ethical and scientific limitations. Notably, 90% of drugs that appear promising in animal tests fail later in human clinical trials; a reminder that a mouse is not a human.
Because bodies-on-chips model human biology at the cellular level, they can reduce unnecessary experiments and generate more accurate results more quickly and cheaply.
“For example, using the commercial Emulate liver chip, researchers identified 87% of the drugs that would have caused liver damage in humans. Strikingly, all the tested drugs had previously passed animal trials but later caused 242 deaths among patients. According to the pharmaceutical company, had this human‑cell‑based liver chip been available at the time, all those patients could have been saved,” says Senior Research Fellow Miina Björninen.

However, bodies-on-chips themselves raise ethical considerations. One concerns the researcher’s responsibility in how the findings are communicated.
“Bodies-on-chips are currently generating significant hype in academia, and many laboratories are developing their own versions to solve similar scientific questions. In such an environment, research results can easily be overstated even though bodies-on-chips genuinely offer many possibilities,” Björninen says.
The cells used for modelling are typically isolated from patients and can be reprogrammed, for example, into brain cells. A very practical ethical question is whether patients fully understand how their donated cells may ultimately be used.
“If we could mechanically replace each brain cell one by one, a more intriguing question emerges: would the person’s soul and identity persist in these artificial brains? This topic is widely discussed, especially in North America. Brain cells are constantly communicating, both in real brains and in models. Could modelled brains then be capable of thought?” Björninen asks.
Ethical concerns also extend to the potential applications of these technologies. In a world increasingly shaped by conflict, one cannot ignore the possibility that such models could be used, for instance, as testing platforms for chemical weapons.
Manufacturing a body-on-a-chip
A body-on-a-chip that models a single organ may sound simple but is anything but. The liver, for example, contains far more than liver cells: it also includes blood vessels, nerves, immune cells and lymphatic tissue.
At its core, the manufacturing process goes like this: The base of the chip is typically made of glass or hard transparent plastic so that it can be imaged under a microscope. Transparency is essential as you must be able to see inside the device.
On top of this base, a transparent, cell‑friendly material is added to form the workspace. The most common and affordable option is polydimethylsiloxane (PDMS), better known as silicone. This soft, flexible, slightly sticky material is cast onto the glass, and cell chambers and microfluidic channels are shaped into it. Construction can also involve techniques such as 3D printing.
Photo: Jonne Renvall/Tampere University
Along with transparency, controlled fluid flow through the channels is another cornerstone of a body-on-a-chip. The simplest way to create this flow is gravity: in the cast mould, the medium chamber holding the nutrient solution is positioned slightly higher than the adjacent chambers. A waste chamber sits lower on the opposite side, allowing liquid to flow naturally downhill. Pumps can also be used, and in some designs the fluid moves on a rocking platform resembling a classic labyrinth game.
Once the structure is in place, it becomes possible to start building features such as blood vessels. Modelling microvasculature is one of Tampere University’s key strengths. The research team was, for example, the first to successfully construct two interconnected vascular networks.
“What is great about vascular cells is that they already know what to do; we just need to create the right conditions for them. In practice, we mix the cells that form the vessel wall with a hydrogel. The hydrogel can be something like fibrin, a substance involved in blood clotting. When this mixture is added to the channels of the body-on-a-chip, the cells start organising themselves under the influence of flow into a functional vascular network,” Björninen explains.
Developing suitable hydrogels, however, is a demanding task and much of that work takes place in Tampere. The hydrogel must be biologically compatible with the cells while also providing mechanical properties that mimic the softness of human tissues. It must be injectable into the chip and capable of supporting the tissue model throughout the entire experiment.

Photo: Jonne Renvall/Tampere University
Standardisation and oxygen control are still challenging
To borrow a familiar expression, the development of bodies-on-chips is still something of a Wild West. Many researchers design their own custom chips tailored to specific research questions even if they may all model the same organ, such as the heart. As a result, conditions, materials and terminology can vary considerably.
“Any chip that differs even slightly and yet is still meant to model the same thing is already too different. This makes comparing results and achieving a statistically meaningful sample size difficult, if not impossible,” Björninen points out.
“We have building standards that specify exactly how a house must be constructed. Bodies-on-chips would need an equivalent level of microscale standardisation” she continues.
As long as standardisation and regulation remain inadequate, bodies-on-chips cannot be fully adopted by fields such as the pharmaceutical industry.
Like all cell‑culture methods, bodies-on‑chips technology also faces a fundamental challenge: controlling oxygen levels. The air around us contains roughly 20% oxygen, and the repeated opening of incubator doors keeps oxygen concentrations inside them close to this same level.
“But in human tissues, oxygen levels are clearly lower, and oxygen has an enormous impact on how cells behave,” Björninen adds.
In 3D structures, however, conditions can sometimes push oxygen levels in the inner regions too low. This is why vascularisation and porosity are so essential.

Photo: Jonne Renvall/Tampere University
However, the real speciality of researchers at Tampere University is their ability to create a controlled oxygen deficiency called hypoxia. Studying hypoxia is particularly important for disease modelling because oxygen deprivation plays a central role in coronary disease, where a blocked blood vessel cuts off oxygen supply to the tissue. In Tampere, the focus has been especially on modelling cerebral and cardiac infarctions.
“But in human tissues, oxygen levels are clearly lower, and oxygen has a huge impact on the behaviour of cells,” Björninen says.
Sometimes, however, the conditions within 3D structures can result in oxygen levels that are too low in the inner regions. This is why vascularisation and porosity are crucial.
“Being able to mimic infarction‑induced hypoxia in tissues using various microfluidic techniques is a major achievement,” Björninen points out.
Researchers at Tampere University have also ventured into an area that has received relatively little attention so far: modelling adipose tissue.
“What makes adipose tissue particularly interesting is the communication between fat cells and nerve cells. In obesity, fat cells grow larger, increasing the distance between cells and blood vessels and creating a hypoxic environment. Because adipose tissue can form within other tissues, such as muscle and liver, it can also induce hypoxia there. This is what we are investigating in our adipose tissue models,” Björninen says.
Creating a body-on-chip
In the video, Doctoral Researcher Kaisa Tornberg demonstrates how a body-on-chip is manufactured.